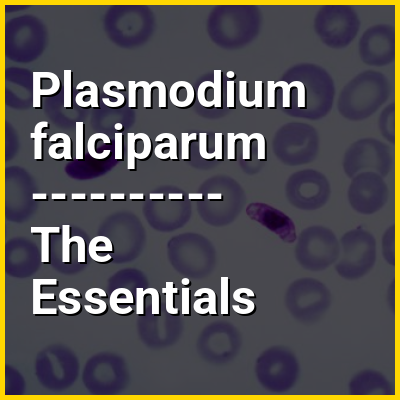

Plasmodium falciparum is a unicellular protozoan parasite of humans and is the deadliest species of Plasmodium that causes malaria in humans. The parasite is transmitted through the bite of a female Anopheles mosquito and causes the disease's most dangerous form, falciparum malaria. P. falciparum is therefore regarded as the deadliest parasite in humans. It is also associated with the development of blood cancer (Burkitt's lymphoma) and is classified as a Group 2A (probable) carcinogen.
The species originated from the malarial parasite Laverania found in gorillas, around 10,000 years ago. Alphonse Laveran was the first to identify the parasite in 1880, and named it Oscillaria malariae. Ronald Ross discovered its transmission by mosquito in 1897. Giovanni Battista Grassi elucidated the complete transmission from a female anopheline mosquito to humans in 1898. In 1897, William H. Welch created the name Plasmodium falciparum, which ICZN formally adopted in 1954. P. falciparum assumes several different forms during its life cycle. The human-infective stage are sporozoites from the salivary gland of a mosquito. The sporozoites grow and multiply in the liver to become merozoites. These merozoites invade the erythrocytes (red blood cells) to form trophozoites, schizonts and gametocytes, during which the symptoms of malaria are produced. In the mosquito, the gametocytes undergo sexual reproduction to a zygote, which turns into ookinete. Ookinete forms oocytes from which sporozoites are formed.